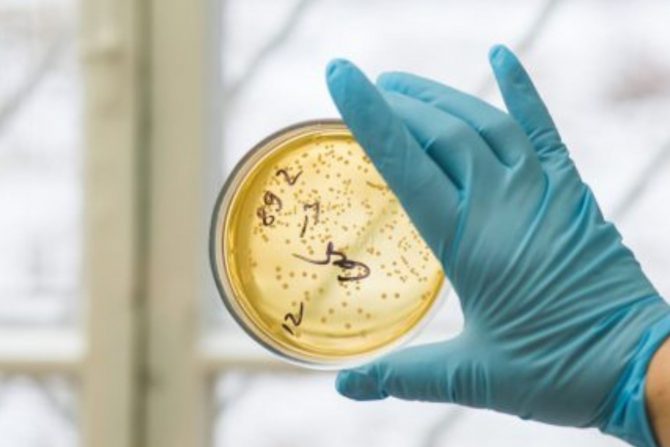
bakterijska infekcija

Bakterijska infekcija uzrok je jednog od 8 smrtnih slučajeva širom sveta
Srčane bolesti odnesu tokom jedne godine najviše života, a odmah posle njih su bakterijske infekcije izazvane jednom od 33 uobičajene vrste bakterija
Bakterijska infekcija je krivac za jedan od ukupno 8 smrtnih slučajeva širom sveta i na drugom su mestu, posle srčanih bolesti, kao vodećih uzroka smrti u svetu, otkriva nova studija objavljena u The Lancet. Kako se navodi u izveštaju, oko 7,7 miliona ljudi umrlo je 2019. od infekcije jednom od 33 uobičajene vrste bakterija, što je skoro 14 odsto smrtnih slučajeva te godine.
Šta je bakterijska infekcija?
Bakterijska infekcija je svaka bolest ili stanje uzrokovano razmnožavanjem bakterija ili otrovima (toksinima) u krvi, koži, crevima (GI traktu), plućima, srcu, mozgu ili bilo gde drugde u telu. Štetne bakterije iz okoline, zaražena osoba ili životinja, ujed bube ili nešto kontaminirano (poput hrane, vode ili površina) mogu da budu uzrok infekcije. Bakterije, koje inače nisu štetne, ali koje dospeju na mesto u telu gde ne bi trebalo da budu takođe mogu da izazovu infekcije.
Bakterijske infekcije izazivaju živi jednoćelijski organizmi koji mogu sami da se razmnožavaju i samo nekoliko vrsta bakterija izaziva bolest kod ljudi, a antibiotici mogu da leče većinu bakterijskih infekcija. Bakterije mogu da izazovu mnoge vrste infekcija, u zavisnosti od izloženosti od toga koji deo tela je zaražen. Neke uobičajene vrste bakterijskih infekcija su:
- Trovanje hranom (gastroenteritis) - infekcije kampilobakterom i salmonelom
- Neke infekcije kože, uha ili sinusa - celulitis, čirevi i impetigo
- Neke polno prenosive infekcije - Hlamidija i gonoreja, polno prenosive infekcije
- Bakterijska pneumonija - pneumokokna bolest, infekcije uha i sinusa i neke vrste pneumonije
- Većina infekcija urinarnog trakta - bakterijska vaginoza, prekomerni rast bakterija u vagini
Jedna od tri bolesti uzrok su 75 odsto smrtnih slučajeva
Prema novoj studiji, više od 75 procenata smrtnih slučajeva zbog bakterijske infekcije uzrokovano je jednom od tri bolesti - infekcije donjih disajnih puteva, infekcija krvotoka i abdominalnih infekcija. A pet specifičnih i generalno dobro poznatih klica - Staphylococcus aureus, Escherichia coli, Streptococcus pneumoniae, Klebsiella pneumoniae i Pseudomonas aeruginosa bile su odgovorne za više od polovine smrtnih slučajeva od bakterijske infekcije. Patogen povezan sa najvećim brojem smrtnih slučajeva u svetu je Staphylococcus aureus - uzrok smrti za 1,1 milion smrtnih slučajeva. Ova bakterija izaziva „stafilokokne“ infekcije koje mogu da dovedu do upale pluća i sepse.
Četiri druge bakterije bile su uzrok više od pola miliona smrtnih slučajeva - E. coli (950.000 smrtnih slučajeva), S. pneumoniae (829.000), K. pneumoniae (790.000) i P. aeruginosa (559.000), saopštili su istraživači.
Bakterijske infekcije ubile su najviše ljudi u Africi
- Novi podaci po prvi put otkrivaju obim globalnog izazova javnog zdravlja koji predstavljaju bakterijske infekcije. Najvažnije je da se ovi rezultati stave na radar globalnih zdravstvenih inicijativa kako bi dublje moglo da se posveti pažnja ovim smrtonosnim patogenima i smanji broj smrtnih slučajeva i infekcija - istakao je dr Christopher Murray sa University of Washington School of Medicine u Sijetlu.
Kako se navodi u studiji, stopa smrtnosti od bakterijske infekcije varirala je u zavisnosti od lokacije. Podsaharska Afrika imala je najviše - 230 smrtnih slučajeva na svakih 100.000 ljudi. Poređenja radi, Zapadna Evropa, Severna Amerika i Australazija (Australija, Novi Zeland, Nova Gvineju i okolna ostrva) imale su kombinovanu stopu od 52 smrtna slučaja na 100.000 ljudi. Bakterije koje su uzrok najvećeg broja smrtnih slučajeva takođe su se razlikovale po godištu ljudi koje su inficirale. Bakterija Staphylococcus aureus izazvala je najviše smrtnih slučajeva kod ljudi starijih od 15 godina, dok je Salmonella enterica serovar Typhi ubila najviše dece, uzrasta od 5 do 14 godina, a najviše dece mlađe od 4 godina ubila je Streptococcus pneumoniae.
eKlinika zadržava sva prava nad sadržajem. Za preuzimanje sadržaja pogledajte uputstva na stranici Uslovi korišćenja.


